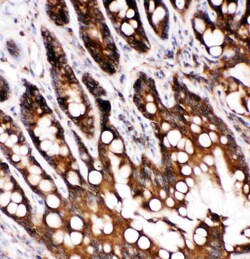

Learn More
                                    Invitrogen™ Caspase 6 p18 Polyclonal Antibody
 
                                    
                                    
                                    
                                    
                                
                            
                            
                            
                            
Rabbit Polyclonal Antibody
Supplier: Invitrogen™ PA578923
Description
Reconstitute with 0.2 mL of distilled water to yield a concentration of 500 μg/mL. Positive Control - WB: Rat Liver Tissue, Rat Kidney Tissue, Rat Testis Tissue, NRK Cell, Mouse Liver Tissue, Mouse Kidney Tissue, Mouse Testis Tissue. IHC: Rat Spleen Tissue, Rat Intestine Tissue, Mouse Lung Tissue IHC-F: Rat Spleen Tissue.
Caspase 6 is an enzyme that in humans is encoded by the caspase 6 gene. This gene encodes a protein that is a member of the cysteine-aspartic acid protease (caspase) family. Using radiation hybrid mapping, the Caspase 6 gene is localized to human chromosome 4q25-q26. Caspase 6 functions as a downstream enzyme in the caspase activation cascade. And Caspase 6 can cleave lamin A to its signature apoptotic fragment. 
            Specifications
| Caspase 6 p18 | |
| Polyclonal | |
| Unconjugated | |
| CASP6 | |
| apoptotic protease MCH-2; CASP6; CASP-6; caspase 6; caspase 6, apoptosis-related cysteine peptidase; caspase 6, apoptosis-related cysteine protease; caspase-6; Caspase-6 subunit p11; Caspase-6 subunit p18; MCH2 | |
| Rabbit | |
| Antigen affinity chromatography | |
| RUO | |
| 12368, 83584 | |
| -20°C | |
| Lyophilized | 
| Immunohistochemistry (Frozen), Immunohistochemistry (Paraffin), Western Blot | |
| 500 μg/mL | |
| PBS with 5mg BSA and 0.05mg sodium azide, 0.05mg thimerosal | |
| O08738, O35397 | |
| CASP6 | |
| A synthetic peptide corresponding to a sequence at the N-terminus of rat Caspase-6 (P18) (7-27aa FYRSREVLDPAEQYKMDHKRR). | |
| 100 μg | |
| Primary | |
| Mouse, Rat | |
| Antibody | |
| IgG | 
Safety and Handling
Your input is important to us. Please complete this form to provide feedback related to the content on this product.